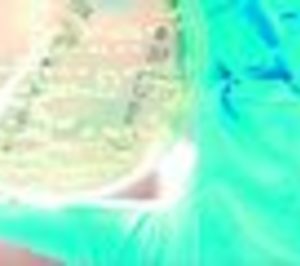
Labco lanza un test en sangre para medir el índice Omega-3

El grupo especialista en análisis clínicos y biológicos Labco ha lanzado al mercado 'Índice Omega-3', una prueba diagnóstica en sangre que mide la presencia de estos ácidos grasos , imprescindibles para la prevención de enfermedades cardiovasculares y cerebrovasculares. El test podrá utilizarse como herramienta de prevención, ya que detecta a tiempo la deficiencia en Omega-3 y permite corregir la desviación con un plan dietético adecuado, cuyos resultados se podrán ir midiendo con análisis periódicos, hasta conseguir los índices óptimos.
El test está indicado para toda la población en general, aunque se recomienda en especial a la población de riesgo, es decir, personas que sufran enfermedades cardiovasculares, dolencias crónicas (como asma, alteraciones metabólicas, inmunológicas o inflamatorias) o pacientes con bajo estado de ánimo o depresión, entre otras.
Encabezado por la mercantil Labco Diagnostics, Labco cuenta en España con 55 laboratorios, de los que 33 son hospitalarios y ocho de anatomía patológica. El resto son centros de atención regional, ambulatorios, o centrales. El grupo Labco registró una facturación sobre 150 M€ en 2012, por su actividad en los mercados de España y Portugal, mientras todo el grupo Labco, con sede en Francia y presencia en siete países de Europa, suma un total de 120 laboratorios en el continente y una facturación de 600 M€ anuales.